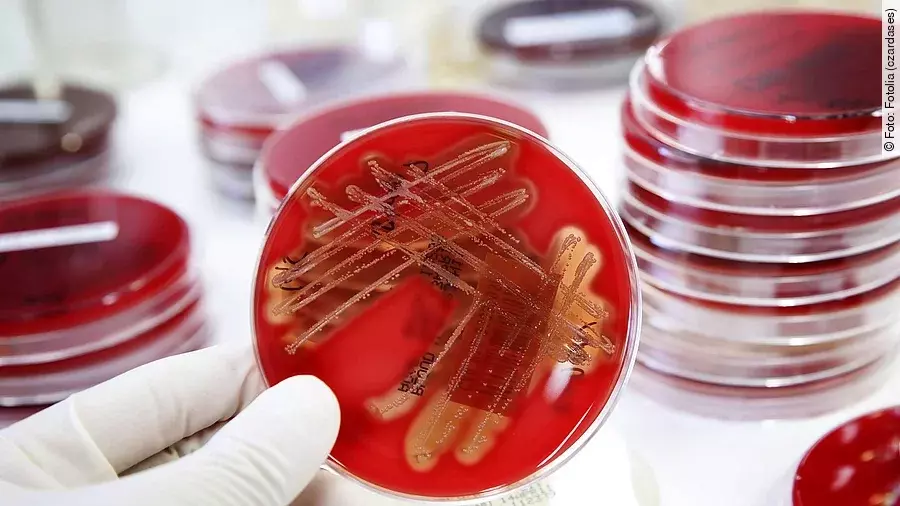
Bakterien

Die internationale Gemeinschaft tut nach Ansicht der Weltgesundheitsorganisation (WHO) viel zu wenig, um neue wirksame Antibiotika zu entwickeln. Aktuell gebe es nur ganz wenige Behandlungsoptionen bei Infektionen mit Antibiotika-resistenten Keimen, teilte die WHO am Mittwoch mit.
Resistenzen gefährdeten ernsthaft den medizinischen Fortschritt, sagte WHO-Chef Tedros Adhanom Ghebreyesus. „Es gibt einen dringenden Bedarf für mehr Investitionen in Forschung und Entwicklung, ansonsten kommen wir wieder in eine Zeit, in der Menschen gewöhnliche Infektionen und kleine operative Eingriffe fürchten“, sagte Tedros. Allein an der behandlungsresistenten Tuberkulose sterben den Angaben zufolge pro Jahr 250.000 Menschen.
Auch andere Krankheiten wie Lungenentzündung oder Infekte der Harnwege würden inzwischen von Keimen ausgelöst, die gegen gängige Antibiotika resistent seien. Von 51 neuen Antibiotika, die laut WHO in der Entwicklung sind, eröffneten nur acht wirklich neue Wege bei der Behandlung. „Pharmafirmen und Forscher müssen sich dringend auf die Entwicklung neuer Antibiotika gegen schwere Infekte konzentrieren, die sonst Patienten innerhalb von Tage töten können“, so die WHO-Expertin Suzanne Hill. Eine entsprechende Forschungspartnerschaft werde von Deutschland und anderen Staaten bisher mit 56 Millionen Euro unterstützt.







Derzeit sind noch keine Kommentare vorhanden. Schreiben Sie den ersten Kommentar!
Jetzt einloggen